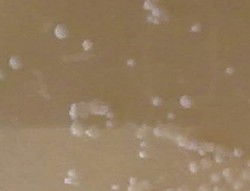

| Nuestro amigo el
lactobacilo.
Alteraciones ocasionadas por microorganismos.
Los enemigos del olivo.
Control biológico de plagas
y otros aspectos ambientales.
Otros aspectos |

Pulse la imagen para ver la cartelería definitiva
|
| Nuestro
amigo el lactobacilo. |

Lactobacilos |

Lactobacilos |

Fermentación |

Glucolisis (+ rótulo fermentación láctica)
|
)
Requerido
|
|

Modelo de la molécula de oleuropeina.
|

Esquema de la fermentación láctica.
|

Modelo de la molécula de oleuropeina en el que se indican
sus constituyentes.
|

Cultivo de lactobacilos. |

Evolución del pH. |

Cultivo de lactobacilos (detalle).
|
|
|
|

Algunos aspectos del proyecto del curso pasado relacionados con los
microorganismos.
|

Lactobacilos (Gram +)
|
|
|
|
|
|
|
|
| |
|
|
|
|
| Alteraciones
ocasionadas por microorganismos. |

Alambrado
|
|

Esquema de la fermentación alcoholíca.
|
|
|

Levaduras (Fermentación alcohólica)
|
|
|
|
|

Comprobando por el olfato el proceso de fermentación (muestra de
fondo) |
|
| Los
enemigos del olivo. |

Escudete |

Escudete |

Negrilla o tizne |

Negrilla o tizne |

Verticilosis |

Verticilosis |
|
|
|
| |

Repilo
|

Repilo
|

Repilo
|

Repilo
|

Repilo
|

Pseudomonas
|

Pseudomonas |

Pseudomonas |

Pseudomonas |

Algunos aspectos del proyecto del curso pasado relacionados con
los microorganismos.
|

Nódulos de tuberculosis |

Nódulos de tuberculosis |

Algunos aspectos del proyecto del curso pasado relacionados con los
microorganismos.
|

Nódulos de tuberculosis |

La verticilosis ocasiona la sequía de las ramas. En este caso
al tratarse de una rama aislada, probablemente sea por otra causa, pero
el aspecto es el mismo.
|

La verticilosis ocasiona la sequía de las ramas. En este caso al
tratarse de una rama aislada, probablemente sea por otra causa, pero el
aspecto es el mismo. |

La verticilosis ocasiona la sequía de las ramas. En este caso al
tratarse de una rama aislada, probablemente sea por otra causa, pero el
aspecto es el mismo. |

Tras el primer paso de la tinción de Gram (I).
(Violeta de Genciana) |

Tras el primer paso de la tinción de Gram (I).
(Violeta de Genciana) |

Aspecto final tras la tinción de Gram (I).
|
|
|
|
|
|
|
|
|
|
|
|
|
|
|
|
| |
|
|
|
|
|
| Control
biológico de plagas y otros aspectos ambientales. |
| 
|

|

Algunos aspectos del proyecto del curso pasado relacionados con los
microorganismos.
|

Bacterias del suelo |
|

Nódulos de Rhizobium |

Rizosfera |

Bacterias sobre hifas |

Nódulos de Rhizobium |

Hifas de Mucor en el suelo
|

Actinomicetos en el suelo (Streptomices)
|

Micorrizas
|

Descomposición de hojas por los hongos
|

Bacterias sobre hifas |
 Micorrizas |

Algunos aspectos del proyecto del curso pasado relacionados con
los microorganismos.
|

Los restos minerales del suelo dificultan la observación.
|

Algunos aspectos del proyecto del curso pasado relacionados con los
microorganismos.
|
 Protozoos |

Vorticela en el suelo |

Ameba fagocitando bacterias |

Muestra de suelo decantada y agitada tras la eliminación del depósito
grueso. |

Raíces sin/con micorrizas (+ estrés)
|

Muestra de suelo decantada y agitada tras la eliminación del
depósito grueso.
|
| |
|
|
|
|
 Prays oleae
Prays oleae |
|
|
|
|
|
|
|
|
|
|
|
| Otros aspectos |

Sonda para extracción de iones. |

Sonda para extracción de iones. |

Sonda para extracción de iones. |